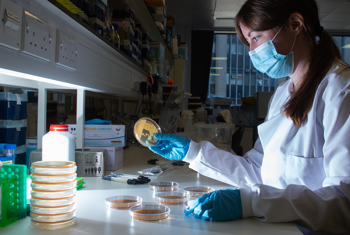

Scientists advise Christmas shoppers to wash their hands to help prevent the spread of bacteria to the vulnerable
Thursday, 1 December 2022
An investigation unveiled potential dangers lurking on self-service screens and handrails as the festive season gets underway
Health chiefs are warning Christmas shoppers to massively step up their hand hygiene after a public health study identified thousands of bacteria living on self-checkouts, including those normally associated with faeces.
Microbes that are commonly found in the intestines and can lead to urinary tract infections (UTIs) were also discovered on swabs taken at self-service points across a number of UK stores as part of the project.
With the festive shopping period in full swing and time-poor consumers opting for speedy self-service checkouts, the Champs Public Health Collaborative is calling on people to take extra care to protect themselves and others as we prepare for the annual spike of winter illnesses such as Norovirus and flu.
As part of the experiment, scientists analysed 19 swabs from a range of other everyday objects such as escalator handrails, public toilet door handles, as well as office computer keyboards, pets and pet toys.
Following examination, the samples revealed thousands of bacteria, including E. coli – a bacteria that can lead to a range of gastro-intestinal illnesses – being present on almost all objects investigated.
A bug commonly found in the vagina, mouth, throat and gut called Candida albicans, which has the potential to cause a yeast infection, was discovered on an escalator handrail, while intestinal microbes that can cause a range of infections in humans, including UTIs were found on computer keyboards.
Dr Adam Roberts, one of the chief researchers within the Infection Innovation Consortium (iiCON), which is led by the Liverpool School of Tropical Medicine (LSTM),
produced the analysis of the bacteria.
Adam, Reader in antimicrobial chemotherapy and resistance at LSTM, said: “We live in a bacterial world – bacteria and microbes are everywhere, and we come into contact with them all day, every day.
“It’s vital to try to minimise their effects in terms of infection prevention and control, so when we touch our mouths or go to the toilet and don’t wash our hands, we’ve likely got bacteria from these places on our hands which can then transfer to other things – and subsequently to other people.
“If those individuals are more susceptible to infection than you are, there may be a problem.
“The self-checkout samples had one of the highest bacterial loads, as we found five different types of potential disease-causing bacteria surviving on them. This included Enterococcus which is found in human faeces and, while this is usually harmless, it can of course lead to disease, particularly in those who may have weakened immune systems.
“We found multiple examples of E. coli and a bacteria called Klebsiella on computer keyboards. While both exist naturally in faeces and intestines, given the right environment, they are able to cause quite severe diseases in humans, so it’s vital that we wash our hands before and after eating when working at the computer.”
Now, as we head further into winter and prepare for a range of infectious diseases to soar, medical experts at Champs Public Health Collaborative – a public health partnership between nine Directors of Public Health across Cheshire and Merseyside – are urging us all to be extra vigilant and keep washing our hands regularly.
It comes as part of a wider campaign, Simple Things, which was launched after researchers found that two thirds of people are worried about the spread of infectious diseases this winter, with younger people having the most concerns.
The Simple Things initiative calls on people to practise four key measures to prevent the spread of winter illness - hand washing, sanitising surfaces, keeping distance when unwell and covering sneezes or coughs.
Matt Ashton, Director of Public Health for Liverpool, is now urging those with vulnerable loved ones in particular to take extra care and ensure their hands are clean before coming into contact with them.
He said: “Our results showed that there are multiple bacteria living on objects that we touch every single day. These bacteria are completely invisible to the naked eye – surfaces may look clean but can be covered in bacteria.
“But there are simple things we can do to prevent the spread of them and stop the transfer completing its cycle. This is particularly important if you are visiting vulnerable relatives in hospitals and care homes, for example.
“Hospital admissions for illnesses like Norovirus and flu always spike at this time of year, but we can take steps to reduce how quickly germs transfer from one person to another, by simply keeping our hands clean – washing them after going to the bathroom and before and after we eat.”
For more information about the Simple Things campaign, visit: www.simplethings-nhs.com